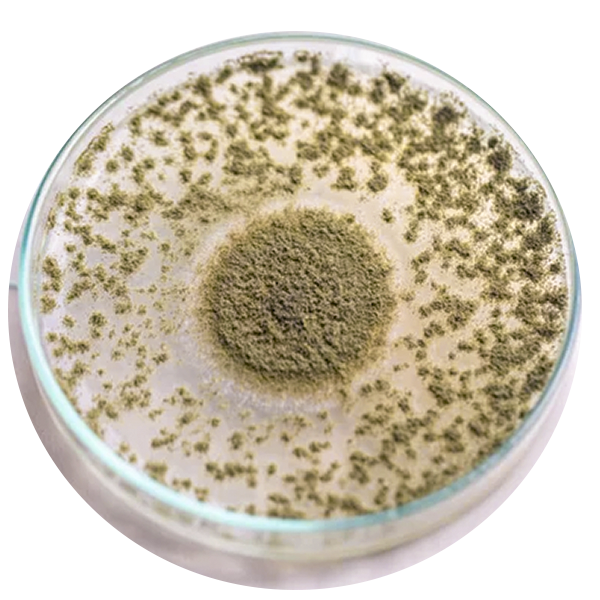

Alimentos balanceados
Planta Productora de Alimentos
Ofrecemos un servicio diferenciado para ganaderos que buscan resultados reales. Desarrollamos alimentos con un perfil nutricional específico, diseñados para satisfacer las necesidades de manejo y maximizar la productividad de tus animales
Alimento Balanceado
Brindamos un servicio diferenciado para ganaderos que buscan sacar el máximo provecho del potencial genético de su hato, desarrollando alimentos con un perfil nutricional específico, formulados según las necesidades reales de manejo y enfocados en aumentar su productividad. ¡Alimentación de precisión, resultados visibles!
GANADO
Alimentos balanceados para vacas.
CONCENTRADOS
Alimentos con un perfil nuticional específico.
GANADO PORCINO
Alimentos diseñados para cubrir las etapas del ganado porcino
Respaldados por más de 49 años de experiencia en nutrición animal de alto nivel para el sector ganadero
Ponemos a disposición de nuestros socios y del público en general un laboratorio de control de calidad con servicios de análisis confiables y precisos para el sector ganadero.
Análisis de laboratorio.
Diseñadas para detectar y cuantificar la presencia de micotoxinas en alimentos, forrajes y materias primas
Con el firme compromiso de ofrecer resultados confiables y oportunos, nuestro laboratorio se apoya en tecnología instrumental de vanguardia y en un equipo altamente calificado, comprometido con el Sistema de Gestión de Calidad. Trabajamos bajo los lineamientos de la Norma Mexicana NMX-EC-17025-IMNC vigente, con el objetivo de garantizar la satisfacción de nuestros clientes y fomentar la mejora continua de nuestros procesos